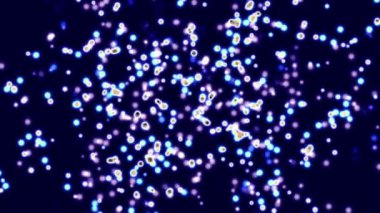
3D render illüstrasyon renkli bakteri

İhlal Bildirim Formu
En Çok Aranan Kelimeler
RenkArkaplanRenkliarka planlaryataydairedekoratifkenaryinelegrafiklerpopHareketGirdap!BasitsüslümalzemeDöndürmeVideodokularDesenlerefektleranimasyonsoyutDöngütasarımlarıgirdapemmeParçacıklarVideolarpiçrotasyonlarpastel renkBirleşiklikhareketli grafiklerarkaplan malzemeleriloop materialVJ malzemeleriBenzer İçerikler